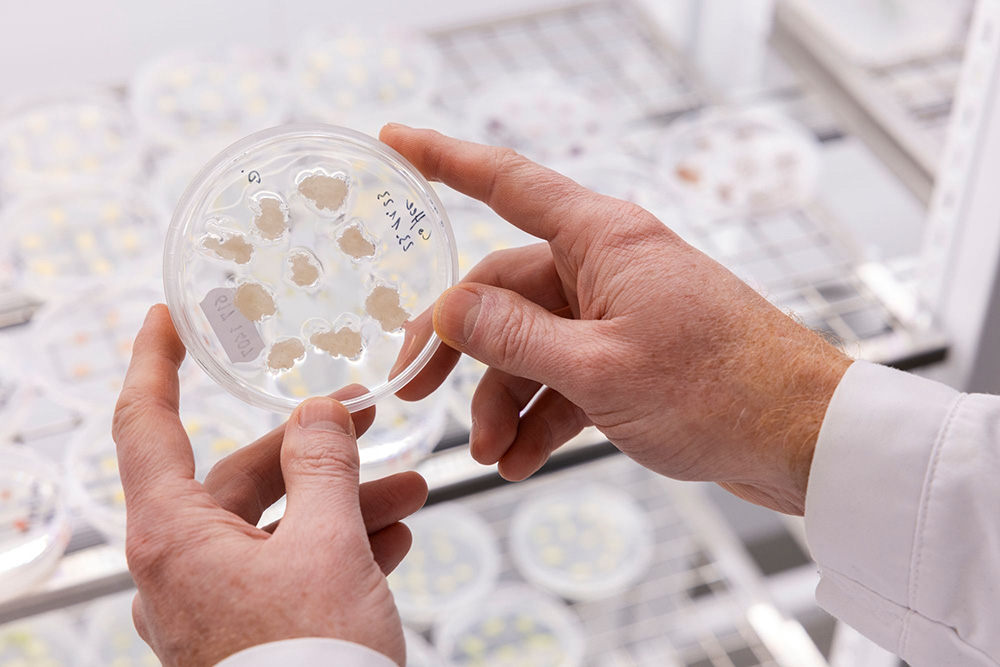
コーヒー豆の細胞が入ったペトリ皿

実現間近?フィンランドのラボ生まれの“細胞培養コーヒー”
Finland [Helsinki]
2025.03.31

text by Asaki Abumi / photoraphs by Vesa Kippola
世界で流通するコーヒーの60%を占めるアラビカ種と40%を占めるロブスタ種は、農薬の使用やさび病などの問題で、今後30年で世界の生産量が半減すると予測されている*1。またコーヒーのカーボンフットプリントは他の農作物に比べて高く、全世界で年間330億~1260億kgのCO2に相当。これはデンマークやフィリピンなど1カ国の年間排出量に匹敵する*2。
北欧ではコーヒーは欠かせない飲み物だ。市民1人当たりの消費量も北欧諸国がトップを占める。だが今年に入り、コーヒーが「高級品」になりつつある変化を肌で感じるようになった。フィンランド公共局YLEは、2024年2月と比べて、コーヒーの価格は20.2%値上がりしたと報じたばかりだ*3。しかもコーヒーの生産には、土地や水の利用、労働者の権利、気候変動など、複数の持続可能性に関する課題がある。それでも北欧市民にとってコーヒーは、毎日飲みたい、愛すべき存在。解決策のひとつとして、代替品の需要が高まっている。
フィンランドでイノベーションを促進するVTT研究機関(VTT Technical Research Centre of Finland)は、コーヒーの細胞培養生産という、驚くべき開発に取り組んでいる。この新技術では、木や果実、豆は存在しない。コーヒーの細胞を培養し、細胞株を確立した後、醸造タンクに似た大型の鋼鉄製の容器「バイオリアクター」内で細胞の合成・分解・生産を行う。バイオマスが出来上がったら「乾燥」させ、加熱して「焙煎」する。焙煎後は従来のコーヒー粉末(挽いたコーヒー豆)のように見え、コーヒーフィルターに入れてお湯で抽出することが可能だ。分析の結果、まだ課題はあるが、従来のコーヒーと同じく様々な味や香りの再現に成功している。

2021年に始まったこの画期的な研究開発は、今も活発に進んでいる。
「コーヒー豆の価格上昇により、この技術への関心が加速し、価格の同等化が容易になりました」と、研究チームリーダーで理学博士でもあるヘイコ・リッシャー氏は取材で答えた。
「コーヒー細胞のような植物細胞は、動物(肉)細胞よりもはるかに簡単に培養できます。複雑な有機培地ではなく、安価な無機培地が使用されるからです。バイオテクノロジーの製品コストは、主に生産規模に依存します。最初は小規模生産のためコストは高くなりますが、生産量が増加するにつれて削減されます。実際、コーヒー豆の価格が上昇しているため、コストの同等化は容易になるでしょう」
世界的に見ても、「細胞培養コーヒー(Cell Culture-Based Coffee)」の開発に取り組む企業は増加傾向にあるという。機密保持のため、顧客企業については公表できないが、2025年2月時点ではまだ製品化はされていない。
「細胞培養コーヒーの品質にも多様性があります。 また、従来のコーヒーよりもカフェインが少ないことがわかっています」(リッシャー氏)

コーヒー豆は年に1~2回収穫できるが、細胞培養コーヒーは、プロセスが管理され細胞が無限に再生可能なため、1カ月で新たなバッチを作ることが可能だ。
コーヒーの香りや品質は多様だからこそ、焙煎業者やコーヒーブランドなど、関係者全員で協力し合い、商品化に必要なプロセスを構築する必要がある。VTT研究所は開発方法を秘密にしているわけではなく、そのプロセスは2023年に科学論文としても発表された。透明性や協働を大切にする北欧らしさともいえるだろう。
気候変動などの世界的な課題に取り組みながら、愛するコーヒーをこれからも飲むためには、選択肢は増える必要がある。未来の道筋を示す細胞培養コーヒーが製品化され、スーパーの棚に並ぶ日も、そう遠くはないかもしれない。

◎VTT Technical Research Centre of Finland Ltd
https://www.vttresearch.com/en
関連リンク
- *1 Springer Nature
A bitter cup: climate change profile of global production of Arabica and Robusta coffee - *2 Geo
Life cycle assessment synthesis of the carbon footprint of Arabica coffee: Case study of Brazil and Vietnam conventional and sustainable coffee production and export to the United Kingdom - *3 フィンランド公共局YLE
- *4 研究論文『Proof of Concept for Cell Culture-Based Coffee』









